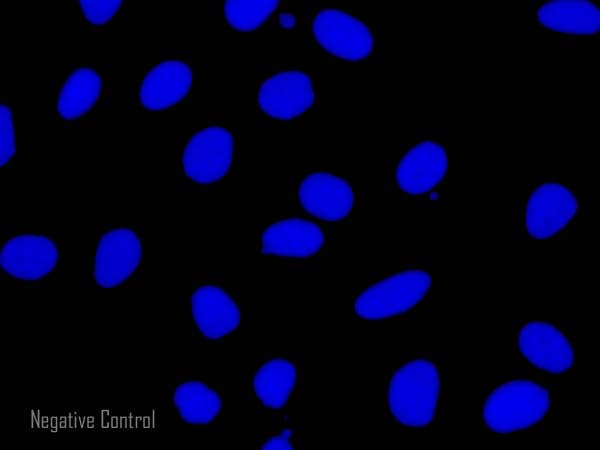
Donkey F(ab')2 Anti-Rat IgG H&L (Alexa Fluor® 488) preadsorbed(AB150149)

Donkey F(ab')2 Anti-Rat IgG H&L (Alexa Fluor® 488) preadsorbed(AB150149)
$undefined

Suitable for ELISA, IHC-Fr, IHC-P, Flow Cyt, ICC/IF. Ideal for fluorescent cell and tissue imaging. Preadsorbed to minimise non-specific binding and high background staining. Cited in 3 publications.
| Shipped At Conditions | Blue Ice |
| Appropriate Long term Storage Conditions | Store at -20°C. |
| Clonality | Polyclonal |
| Applications | ELISA, Flow Cyt, ICC/IF, IHC-Fr, IHC-P |
| Isotype | IgG |
| Conjugation | Alexa Fluor® 488 |
| CAS Number | Heavy & Light chains |